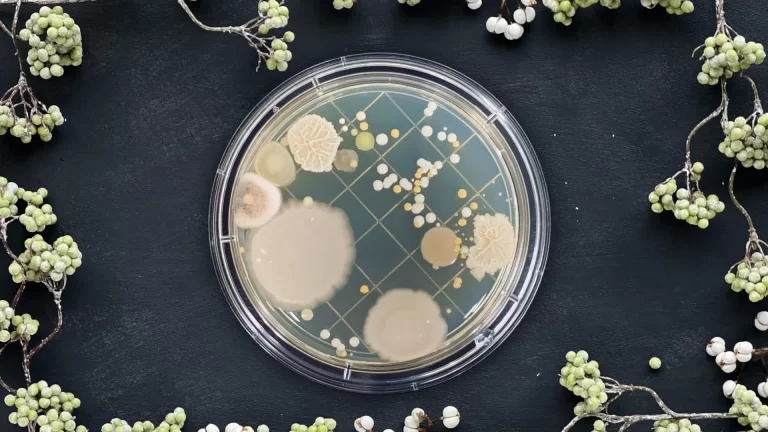
培養法による食品細菌検査のイメージ画像。黒い机の中央に、微生物のコロニーが生えた寒天培地が置かれ、その周囲を植物が取り囲み、装飾しています。

食品のDNA分析に関する技術や最新の動向について、わかりやすくご紹介します。
内容は随時更新してまいります。
「遺伝子組換え」で作物に付与される能力とは?
遺伝子組換え(GMO)は食や環境にどう役立つ?農作業を効率化する除草剤耐性や病害虫抵抗性、栄養価を高める組成改変、アレルギー物質を減らす技術まで、7つの目的別に付与される能力を一覧で紹介。食料・環境問題の解決に貢献し、私たちの未来を変える可能性を秘めた遺伝子組換え技術の今とこれからを解説します。 …
細菌検査におけるDNA分析の活用(培養法との比較編)
食品業界では近年、「高感度」「迅速」といったキーワードで「DNA分析」ベースの細菌検査が大きな注目を集めています。従来主流だった「培養法」とは何が異なり、どのように使い分けるべきなのでしょうか。本稿では、それぞれの手法について技術的・運用的な差異を整理し、DNA分析の真価が発揮されるシーンについても …
なにができる?食品のDNA分析
DNA分析は、食品産業でどのように活用できるのでしょうか。検出・測定・識別・調査の4つの柱で徹底解説。アレルゲン検出や原材料偽装防止、トレーサビリティ、機能性食品開発など、食品業界で注目のDNA分析技術のメリットや活用ポイントを分かりやすく紹介します。 …